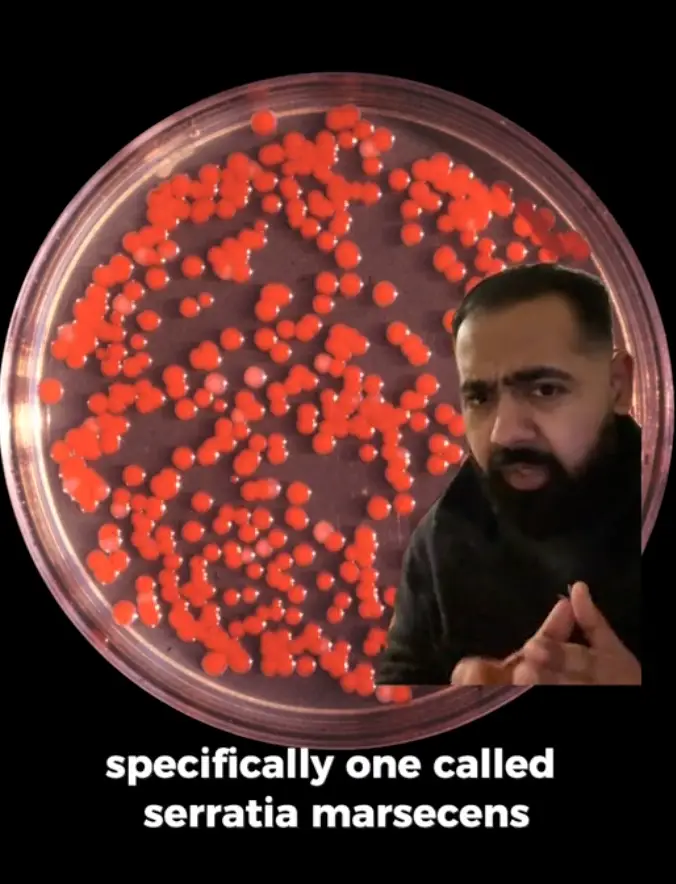
Yes, it's bacteria (TikTok/ @dr.karanr)

Thought you could just ignore that pink slime lingering around your shower drain? Think again.
A doctor has taken to TikTok to warn about 'pink slime' which may rear its head in your bathroom, and why it could actually signal a bigger issue.
Dr Karan Raj took to his platform to warn about the 'pink slime', after another user revealed they'd ended up in hospital as a result of not 'clean[ing] the pink mould out of the uni accom showers'.
Dr Karan responded: "If you've seen this pink slime lurking in your bathroom it's not mould - it's bacteria."
The doctor revealed the pink stuff you may spot around your drains or crevices in your bathroom is actually a bacteria called 'serratia marcescens'.
Look familiar? (TikTok/ @dr.karanr) Dr Karan says the bacteria can 'vomit hot pink all over your bathroom'.
"This bacteria loves damp, moist places, and enjoys munching on fatty deposits like those found in soaps and shampoos hence why it likes to hang out in your bathoom," he explains.
Infectious Disease Advisor adds: "It can be found in soil, water, plants, and animals.
"In homes and hospitals, it may be found in the corner of wet showers or wash basins, where it is visible due to the red-colored pigment (prodigiosin) it produces."
Dr Karan reassures 'for the average person' the bacteria is 'pretty harmless even if you come into contact with it'.
"But you still want to avoid getting it in your eyes or open wounds," he notes.
Yes, it's bacteria (TikTok/ @dr.karanr) Infectious Disease Advisor warns it can be dangerous when hospitalized patients or those who are immunocompromised or critically ill come into contact with it, particularly as it's 'often resistant to multiple antibiotics, which can make it difficult to treat'.
Dr Karan explains it can specifically cause 'gut, urine or chest infections' in those who's immune systems are compromised.
He adds: "If your home has enough damp for pink slime to consistently develop, you could actually be growing other things as well, like actual household mould which could be causing respiratory issues or allergies."
But what can you do about it?
Well, Dr Karan advises: "The first rule of Pink Slime Club is to keep the bacteria from forming in the first place.
"By curbing its growth, you'll be preventing other dangerous moulds from forming as well."
To do this, he suggests keeping your shower room well ventilated, inputting an exhaust fan or opening a window whenever it gets too steamy.
Oh, and get the disinfectant out, and give it all a good scrubbing to as well.

 Poppy Bilderbeck
Poppy Bilderbeck